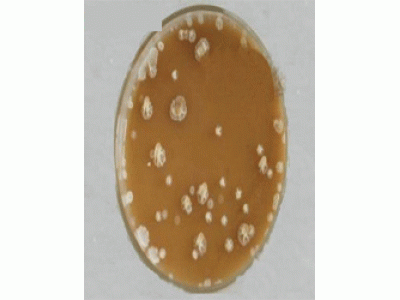

应用范围
枯草芽孢杆菌不仅在饲料中应用比较广泛,在污水处理及生物肥发酵或发酵床制作中应用也相当广泛,是一种多功能的微生物 メイリン モデルコレクション メ。
1,市政和工业污水处理,工业循环水处理,腐化槽、化粪池等处理,畜牧养殖动物废料、臭味处理,粪便处理系统,垃圾、粪坑、粪池等处理; 日本乱妇乱熟乱妇乱色A片.
2,畜牧、家禽、特种动物及宠物养殖,水产养殖; 人妻公妇公侵HD中字.
3 メイリン モデルコレクション メ,可以与多种菌种混配,在农业生产中具有重要作用。。
邮 箱:info@www.zgnong.com
手 机:13803170977
电 话:0317-2052600
地 址:河北省沧州市运河区西屯工业园区

应用范围
枯草芽孢杆菌不仅在饲料中应用比较广泛,在污水处理及生物肥发酵或发酵床制作中应用也相当广泛,是一种多功能的微生物 メイリン モデルコレクション メ。
1,市政和工业污水处理,工业循环水处理,腐化槽、化粪池等处理,畜牧养殖动物废料、臭味处理,粪便处理系统,垃圾、粪坑、粪池等处理; 日本乱妇乱熟乱妇乱色A片.
2,畜牧、家禽、特种动物及宠物养殖,水产养殖; 人妻公妇公侵HD中字.
3 メイリン モデルコレクション メ,可以与多种菌种混配,在农业生产中具有重要作用。。
©2026 河北世翔生物技术有限公司 @sales@www.zgnong.com-- 技术支持:米拓建站 7. 3 人妻公妇公侵HD中字. 0 XML地图 .